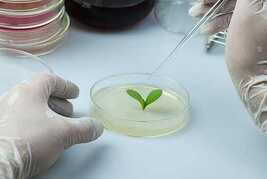
Item image 6

Carnivorous Plant Pre-Transplant Medium and similar items
Envío gratis
Carnivorous Plant Pre-Transplant Medium Powder – Basal Formula for Plantlets
$539.91 MXN - $726.40 MXN
(It may be possible to pay only $20.26 instead of $28.95 when you
use your bCredits at checkout)
Sign up and get $5.00 bCredits free to use at checkout and another $5.00 bCredits when you make your first purchase. More info
Share & earn! Sign in, share this or any listing, and you’ll get commission when it sells.
Learn more
View full item details »
Las opciones de envío
Estimado para llegar por Mon, Dec 8th.
Detalles
Calculado por USPS en MX.
Los buques de
United States

La política de devoluciones
Refunds available: See booth/item description for details
Detalles
Protección de compra
Opciones de pago
PayPal accepted
PayPal Credit accepted
Venmo accepted
PayPal, MasterCard, Visa, Discover, and American Express accepted
Maestro accepted
Amazon Pay accepted
Nuvei accepted
View full item details »
Las opciones de envío
Estimado para llegar por Mon, Dec 8th.
Detalles
Calculado por USPS en MX.
Los buques de
United States

La política de devoluciones
Refunds available: See booth/item description for details
Detalles
Protección de compra
Opciones de pago
PayPal accepted
PayPal Credit accepted
Venmo accepted
PayPal, MasterCard, Visa, Discover, and American Express accepted
Maestro accepted
Amazon Pay accepted
Nuvei accepted
Rasgos del artículo
| Categoría: | |
|---|---|
| cantidad disponible: |
10 En stock |
| Condition: |
New |
| UPC: |
Not Applicable |
| Country/Region of Manufacture: |
United States |
| Style: |
Medium Toast |
| Brand: |
Forest Organics |
| Types: |
Detalles del anuncio
| Las políticas del vendedor: | |
|---|---|
| Envío de descuento: |
Vendedor paga el envío para este artículo. |
| Precio de descuento: |
15% De descuento w / $150.00 pasó |
| Publicado en venta: |
November 6 |
| Artículo número: |
1777628572 |
Descripción del Artículo
This pre-transplant basal medium powder helps Venus Flytraps, Sundews, and other carnivorous plants transition from in vitro culture to soil. It strengthens root systems and supports acclimation during transplant.
Key Features:
Supports acclimation of young carnivorous plantlets
Strengthens root development before soil transfer
Pre-measured powder for easy prep
Reliable formula for enthusiasts and labs
Perfect for Venus Flytraps Sundews
Loading
Este artículo ha sido añadido a su carrito
 Carnivorous Plant Pre-Transplant Medium Powder – Basal Formula for Plantlets added to cart.
10 Disponible en stock
Carnivorous Plant Pre-Transplant Medium Powder – Basal Formula for Plantlets added to cart.
10 Disponible en stock
Ver el carro o seguir comprando.
 Por favor, espere mientras termine de agregar este artículo a su carrito.
Por favor, espere mientras termine de agregar este artículo a su carrito.
Get an item reminder
We'll email you a link to your item now and follow up with a single reminder (if you'd like one). That's it! No spam, no hassle.
Already have an account?
Log in and add this item to your wish list.